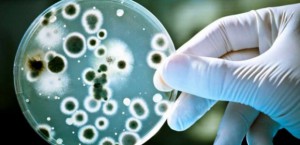
candida-rakovina-sa-da-liecit-620x300.jpg

David Icke: Rakovina je huba, a je liečiteľná
David Icke: Rakovina je huba, a je liečiteľná
Neuveriteľné čísla: Osem miliónov ľudí zomrie každý rok na rakovinu po celom svete. Očakávaný nárast úmrtí v roku 2030 - 12 miliónov ľudí. Rakovina je hlavnou príčinou úmrtí vo vekovej skupine do 85 rokov. V priemere v ľudskej spoločnosti zomrie na túto chorobu každý štvrtý človek.
A prečo spomínam túto skutočnosť? Pretože na konferencii v roku 1969 dr. Richard Day oznámil okrem iného aj toto:
V súčasnej dobe sme schopní vyliečiť akýkoľvek typ rakoviny.
Farmaceutické firmy sa vraj vôbec nemajú pokúšať liečiť tieto ochorenia. Vlastne prečo liečiť skutočne a pravdivo také ochorenie, keď môžu z dôverčivých ľudí vytiahnuť neuveriteľné množstvo peňazí v boji proti symptómom tejto choroby. V tomto prípade nie je potrebné oznamovať dôverčivým ľuďom, že jedy obsiahnuté v chemoterapii môžu zabíjať ako rakovinové, tak aj zdravé bunky, čo má v mnohých prípadoch za následok urýchlenie smrti. Myslím, že uvažujete veľmi správne - tu nejde snáď ani o peniaze, ale ide o to jednoducho znížiť populáciu, a preto je nevyhnutné, aby ľudia trpeli a umierali predčasne.
A ak sa lekárom náhle otvára nejaký efektívny spôsob liečby rakoviny, potom sa prakticky okamžite stáva obeťou nevyberaného útoku rôznorodých zdravotníckych inštitúcií a ďalších oficiálnych štruktúr "systému moci". Napríklad Talian dr. Tullio Simoncini. Tak dlho sa staval proti globálnym mocenským štruktúram, až ho začali prenasledovať zo všetkých strán, až nakoniec skončil na dobu troch rokov vo väzení. A to z toho dôvodu, že začal úspešne liečiť ľudí v posednej fáze rakoviny.
Jeho previnením bola skutočnosť, že si uvedomil, že za zhubnými nádormi stojí rozvoj hubovitej plesne zvanej "candida" (kvasinkový typ huby, ktorá má parazitnú povahu, žije aj v tele zdravých osôb, ale kvalitný imunitný systém udržuje tohto parazita v šachu, ale ak je organizmus dlhodobo oslabený, začne sa huba šíriť po celom tele a môže spôsobovať zhubné nádory).
K tejto veci sa vyjadruje dr. Mike Lambert z "Shen Clinic":
Rôznorodé plesne a huby, predovšetkým však typu candida, žijú v tele hostiteľa. Tento organizmus, rovnako ako iní paraziti, pre svoje prežitie potrebuje hostiteľa. Odpadové produkty kvasiniek oslabujú imunitný systém a vedú k tomu, že sa človek cíti zle, a to ako psychicky, tak aj fyzicky.
Tullio Simoncini hovorí, že rakovinu spôsobuje, rozvoj huby "candida" s tým, že tradičné vysvetlenie tohto ochorenia je úplne mylné. On sám ako odborník v odbore onkológia a metabolických porúch šiel proti intelektuálnej konformite tradičnej medicíny a proti tradičným metódam "liečenie". Proste sa rozhodol povedať svojim pacientom pravdu, a nie len opakovať zažité frázy naučené počas štúdií medicíny.
V podstate od chvíle, kedy sa začal venovať lekárskej praxi, si dnes a denne uvedomoval, ako ľudia postihnutí týmto ochorením trpia.
V detskom onkologickom oddelení, kde som pracoval, postupne všetky deti zomreli. Svojím spôsobom som tušil, že im k tomu dopomohlo veľkým dielom aj ožarovanie a chemoterapia.
Túžba pomáhať pacientom ho viedla k hľadaniu nových spôsobov ako túto chorobu liečiť. Preto sa Simoncini rozhodol vzdať všetkého, čo doteraz vedel o rakovine, a začal svoj nezávislý výskum. Postupne zistil, že všetky nádory sa prejavujú rovnako bez ohľadu na to, v akom orgáne alebo tkanive sa nádor tvorí. Všetky zhubné novotvary mali bielu farbu. Simoncini začal premýšľať, čo by to mohlo znamenať. A potom prišiel na hubu candida. Ďalej si položil otázku: "To, čo tradičná medicína považuje za nekontrolovateľné delenie buniek, môže byť nejakým procesom, ktorým sa organizmus vlastne chráni proti rozvoju kandidózy?
Ak vychádzame z uvedených predpokladov, dostaneme sa k týmto bodom:
a) Huba Candida, ktorá je za normálnych okolností kontrolovaná silným imunitným systémom, sa začína množiť a v oslabenom tele vytvárať mohutné kolónie.
b) V tom okamihu sa imunitný systém snaží všetkými prostriedkami zabrániť ďalšiemu šíreniu tohto parazita, ale sám nemá dostatok síl.
c) Imunitný systém spustí proces extrémne rýchleho množenia buniek a tým sa snaží vybudovať ochrannú bariéru proti votrelcom. Tradičná medicína tento stav nazýva rakovinou.
Všeobecne sa tiež má zato, že proces šírenia metastáz v tele je spôsobený roznesením malígnych buniek do orgánov a tkanív. Ovšem Simoncini uvádza, že metastázy sú spôsobené hubou Candida. Huba môže zničiť bunky normálne fungujúceho imunitného systému. Imunitný systém je kľúčom bunkovej regenerácie. Bohužiaľ každým rokom sa počet pacientov s rakovinou zvyšuje. V skutočnosti ide o veľmi dobre naplánovanú vojnu proti imunitnému systému.
Imunitný systém sa oslabuje nevhodným stravovaním, rôznorodými pridanými potravinárskymi látkami, pesticídmi a herbicídmi, očkovaním, elektromagnetickou a mikrovlnou technológiou, liekmi alebo stresom moderného života. Nemožno zabúdať tiež na to, že deti do dvoch rokov veku svojho života mnohokrát prijmú až 25 rôznych druhov očkovaní, ale v tejto dobe sa práve buduje ich imunitný sytém.
Plán globálneho vládnuceho systému je prostý - znížiť ľudskú populáciu prostredníctvom oslabeného imunitného systému človeka. Ak niekde nestačí rozvrátený imunitný systém, tak dielo dokoná chemoterapia alebo rádioterapia. Najúčinnejšie metódy ako zničiť bunky v tele. Väčšina moderných "liekov" na rakovinu je postavená na predpoklade, že sa u pacienta podarí rakovinové bunky zabiť skôr ako tie zdravé.
V skutočnosti sa má však situácia podstatne inak.
Toxické látky počas chemoterapie zabíjajú bunky imunitného systému, ale pleseň candida sa šíri ďalej. Fragmenty imunitného systému nie sú schopné ovládať bunky Candida. Huba sa šíri do ďalších a ďalších orgánov a tkanív. Rakovina sa šíri telom. Tí, ktorí sa zdajú byť po operácii alebo chemoterapii zachránení, sú v skutočnosti časovanou bombou. Imunitný systém je zničený. Takže recidíva je len otázkou času.
Chemoterapia môže byť úspešná v prípade rýdzo infekčných chorôb alebo sexuálne prenosných ochorení. Aby človek mohol byť vyliečený z rakoviny, musí byť u neho extrémne posilnený imunitný systém, a nie ešte oslabený. Keď Simoncini zistil, že rakovina je v podstate plesňové ochorenie, začal hľadať účinné fungicídne lieky. Lenže sa zároveň ukázalo, že fungicídne lieky nefungujú, ako by mali. Candida rýchlo mutuje a vie sa účinným spôsobom prispôsobiť danému lieku.
Lekár nakoniec zistil, že sa pleseň nedokáže adaptovať na prítomnosť hydrogénuhličitanu sodného, ktorý je hlavnou zložkou jedlej sódy. Z nejakého dôvodu sa huba nedokáže prispôsobiť prostrediu, ktoré aktivuje menovaná látka. Simoncini tak začal svojim pacientom vpravovat do tela roztok hydrogénuhličitanu sodného, ktorý bol vstrekovaný priamo do nádoru prostredníctvom nástroja, ktorý sa podobal endoskopu.
Výsledky na seba nenechali dlho čakať.
V roku 1983 dr. Simoncini liečil taliansku ženu, ktorá sa volala Gennaro Sangemano, ktoré lekári predpovedali smrť v priebehu niekoľkých mesiacov. Trpela rakovinou pľúc. V rukách Simonciniho sa však v pozoruhodne krátkom čase uzdravila. Množstvo následných testov nepotvrdilo prítomnosť rakoviny. Lekár posilnený úspechom začal praktizovať túto metódu aj s ostatnými pacientmi a opäť s veľkým úspechom.
Nakoniec sa rozhodol, že prednesie svoje závery talianskemu ministerstvu zdravotníctva v nádeji, že bude zvolané oficiálne klinické štúdie. Aké však bolo Simonciniho prekvapenie, keď talianske ministerstvo zdravotníctva nielenže neschválilo požadované klinické testovanie, ale zároveň ho zažalovalo a pripravilo o jeho lekársku licenciu v zmysle toho, že liečil pacientov neschváleným postupom. A sme u podstaty veci. Takže my, ľudia, sa jednoducho môžeme nechať liečiť len metódami, ktoré schvaľuje globálny mocenský systém. V opačnom prípade sa každý lekár, ale v podstate ktokoľvek vystavuje nebezpečenstvu perzekúcie zo strany novodobej mocenskej inkvizície.
Masmédiá (vlastnené samozrejme opäť jedným a tým istým mocenským systémom) začali nevyberanú kampaň zosmiešňovania, takže v podstate nebolo dňa, aby Simoncini nebol vláčený v tlači. A všetko vyvrcholilo vykonštruovaným prípadom zabitia pacientky, takže tento talentovaný doktor vyfasoval tri roky "na tvrdo". Súbežne vydali zdravotnícke inštitúcie vyhlásenie, že spôsob liečby rakoviny prostredníctvom roztoku hydrogenuhličitanu sodného je "bláznivý" a "nebezpečný". V čase, keď milióny pacientov zomrú bolestivou smrťou "osvedčenou" a "bezpečnou" chemoterapiou. Našťastie sa Tullio Simoncini nenechal zastrašiť. Potom, čo bol prepustený z väzenia, pokračoval vo svojej práci. Jeho špeciálna metóda vraj slávi veľké úspechy. V niektorých prípadoch trvá procedúra niekoľko mesiacov a v iných prípadoch (napríklad v prípade rakoviny prsníka) niekoľko týždňov. Simoncini často radí ľuďom aj po telefóne alebo e-mailom. Je veľmi ústretový ku každej žiadosti.
Tu je internetová stránka dr. Tullia Simoncini: curenaturalicancro.com
Stlačením záložky "contact" je možné lekára osobne písomne kontaktovať so svojou žiadosťou.
Poďme sa však vrátiť k našej téme. Nie je to totiž zďaleka všetko.
Rakovinové bunky obsahujú jedinečný biomarkerový enzým "CYP1B1". Enzýmy sú bielkoviny, ktoré katalyzujú chemické reakcie. "CYP1B1" mení chemickú štruktúru látky zvanej "salvestrol", ktorá sa nachádza v mnohých druhoch ovocia a zeleniny. Chemická reakcia prevedie "salvestrol" do komponentu, ktorý rakovinové bunky zabijú bez poškodenia tých zdravých.
"CYP1B1" je teda enzým, ktorý je produkovaný iba v rakovinových bunkách a reaguje sa "salvestrolem", ktorý je prítomný v ovocí a zelenine, a tvorí tak látku, ktorá pôsobí iba na rakovinové bunky ".
Toto je veľmi dôležité zistenie, ktoré zároveň objasňuje, prečo je tak dôležité pre osoby postihnuté rakovinovým ochorením piť čistú šťavu z ovocia a zeleniny!
Zároveň je dôležité vedieť, že "salvestrol" vzniká v rastlinách, ktoré sú samé napadnuté plesňovým ochorením. Salvestrol je v podstate produktom imunitného systému týchto rastlín.
Salvestrol je prírodná ochranná látka, ktorá sa nachádza v ovocí a zelenine. Je veľmi úspešná v boji proti plesňovým parazitom. Je zistené, že čím viac je plesňových ochorení v organizme rozšírených, tým masívnejšie salvestrol proti danému škodcovi pôsobí. Veľmi veľké množstvo tejto látky obsahujú tieto plody týchto rastlín: jahody, čučoriedky, maliny, hrozno, čierne ríbezle, červené ríbezle, černice, brusnice, jablká, broskyne, marhule a ďalej brokolica, kapusta, artičok, červená a žltá paprika, avokádo, špargľa a baklažán.
Ale presne toto nadnárodné poľnohospodárske a farmaceutické korporácie riadené globálnym vládnucim systémom veľmi dobre vedia. A preto neváhajú investovať obrovské peniaze do nasledovných aktivít:
a) Vyvíjajú a produkujú chemické fungicídy, ktoré zabíjajú plesne a huby, a zabraňujú tak vzniku prirodzenej ochrany (salvestrolu) v rastlinách v reakcii na plesňovú infekciu. Salvestrol obsahujú iba plody, ktoré neboli ošetrené chemickými fungicídmi!!! Zabudnite teda na nákup ovocia a zeleniny v klasických obchodnom reťazcoch, kde je ovocie a zelenina pod režimom kontroly.
b) Prakticky všetky fungicídy blokujú produkciu "CYP1B1". Preto, ak budete jesť chemicky spracované ovocie a zeleninu, tak bez potrebných pozitívnych účinkov
A ešte jedna dôležitá informácia na záver:
Huby a parazitické plesne sa začínajú množiť v tele, keď sa človek nachádza v tzv dlhodobom oxidatívnom strese. Strážte si, prosím, svoju acidobázickú rovnováhu v tele!